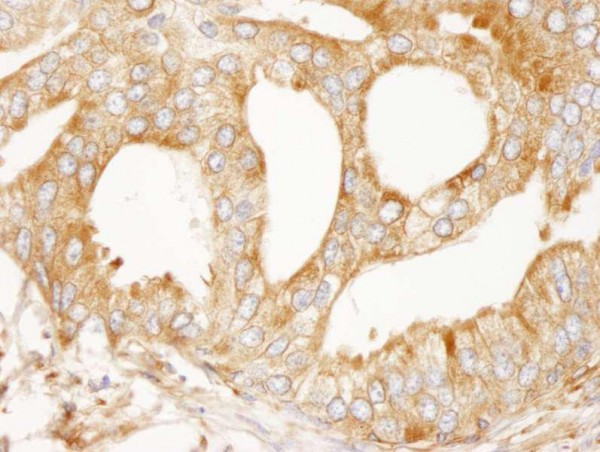
Anti-MAP4 (IHC)

| Artikelnummer | Größe | Datenblatt | Manual | SDB | Lieferzeit | Menge | Preis |
|---|---|---|---|---|---|---|---|
| IHC-00532-T | 10 µl (1 µg) | - |
2 - 8 Werktage* |
165,00 €
|
|||
| IHC-00532 | 100 µl (10 µg) | - |
2 - 8 Werktage* |
621,00 €
|
Bei Fragen nutzen Sie gerne unser Kontaktformular.
Bestellen Sie auch per E-Mail: info@biomol.com
Größere Menge gewünscht? Bulk-Anfrage
Bestellen Sie auch per E-Mail: info@biomol.com
Größere Menge gewünscht? Bulk-Anfrage
Zuletzt angesehen